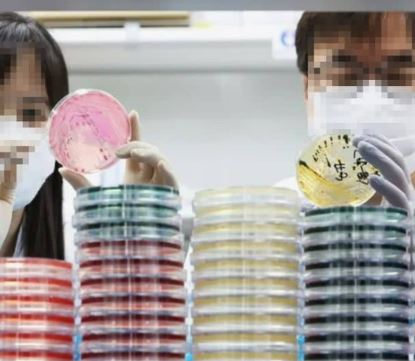
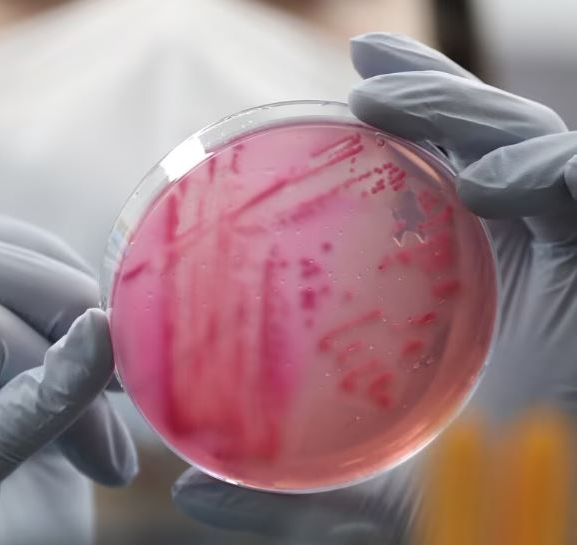
전북 남원 식중독 집단 급식 1000명

지난 3일 전남 남원 지역에서 식중독 의심 환자가 발생했다는 보도가 전해진 가운데 사흘새 식중독 의심 환자가 1000명을 넘겼다는 소식입니다.
전북 남원 식중독 사태로 1000명 집계




지난 3일 전남 남원시에 위치한 초중고교에서 15개 학생들과 교사들에게서 166명의 식중독 의심 증상을 보였다고 밝혔습니다. 해당 소식을 전한 전북도교육청에 따르면 이날 오전 148명은 귀가 조치되었으며, 18명은 입원 치료가 진행 중입니다.
남원 식중독 사태의 첫 신고는 전날 오후 6시에 접수되었으며, 당일 점심 식사를 마친 이후 오후부터 구토를 시작으로 설사와 복통, 발열 증세까지 보였다고 전해집니다.
식중독 의심 증상을 보인 학생들과 교사들이 속해 있는 여러 학교들 중 1개교는 재량 휴업을 결정했고, 9개교에서는 단축수업을, 4개교에서는 기말고사를 연기하는 행정적 조치가 취해졌습니다.
현재 식중독 환자들이 집중 치료를 받고 있는 곳은 전북도 출연 의료기관인 남원의료원으로 재난의료 대응체계가 가동된 상황입니다.
또한 지난 3일에는 166명의 식중독 의심 환자가 집계되었지만 오늘 6일 남원시의 보도에 따르면 오후 1시 기준 현재 1024명으로 잠정 집계되었습니다. 사흘새에 약 800명 넘게 늘어난 것으로 발생 학교수는 기존의 15곳에서 24곳으로 확대되었습니다.
남원 집단 급식 식중독으로 재난안전본부 가동

보건당국은 식중동 의심 환자가 집계된 각 학교의 식단표를 비교하여 공급 업체 조사에 나섰습니다. 전북교육청과 남원시보건소는 환자들의 급식, 조리 기구에서 검체를 채취하여 보건환경연구원에 정밀 검사를 의뢰하여 역학조사를 진행했습니다.
현재까지 밝혀진 바에 의하면 이들 학교가 공통적으로 납품받은 김치에서 바이러스가 검출되었습니다. 공통으로 납품받은 김치에서는 '노로바이러스'가 검출되었으며, 남원시는 해당 업체의 모든 제품들에 대해 제조와 유통, 판매 중단 조치를 내렸습니다.
남원시는 남원시장을 본부장으로 하는 재난안전대책본부를 가동하였으며, 감염병 대응을 위해 질병청, 전북자치도, 전북자치도교육청, 남원교육지원청, 전북감염병관리지원단 등 관련기관과 긴밀한 합동 상황 회의 등을 진행하고 있습니다.
또한 남원시 측에서는 명확한 원인을 규명하기 위해 추가적인 조사를 계속 진행하겠다고 밝혔으며, 식중독의 확산을 방지하기 위해 총력을 다하겠다고 말했습니다.
한편 학사일정을 조정한 각 학교들은 급식을 잠정 중단하고 대체식을 마련하기로 결정했다고 전해졌습니다.

📌 함께 보면 좋은 글
손흥민 축구장 경찰 소동으로 근황 전해
지난 5일 저녁 손흥민이 일반인 축구장에 나타났다는 소식에 모여든 인파 때문에 경찰이 출동하는 일까지 벌어졌다는 소식입니다. 손흥민 축구장 경찰 소동까지 번져축구 국가대표팀 손흥민
1.nadanadago.com
시청역 쪽지 자수 20대 남성으로 밝혀져 충격
지난 1일 서울 중구 태평로에서 발생한 시청역 참사로 보행자 9명이 숨지고 7명이 다치는 사고가 발생했습니다. 추모 공간이 마련된 곳에 "토마토 주스가 돼 버린 분들의 명복을 빈다"는 글을 남
1.nadanadago.com
리사 보상 태국 상인들에게 한달치 급여 지불한 이유
블랙핑크의 멤버 리사가 태국 상인들에게 약 한 달 치 급여를 지불했다고 알려져 화제를 모으고 있습니다. 리사 보상으로 한달치 급여 지불하다최근 블랙핑크 멤버들의 솔로 컴백 소식이
1.nadanadago.com
댓글